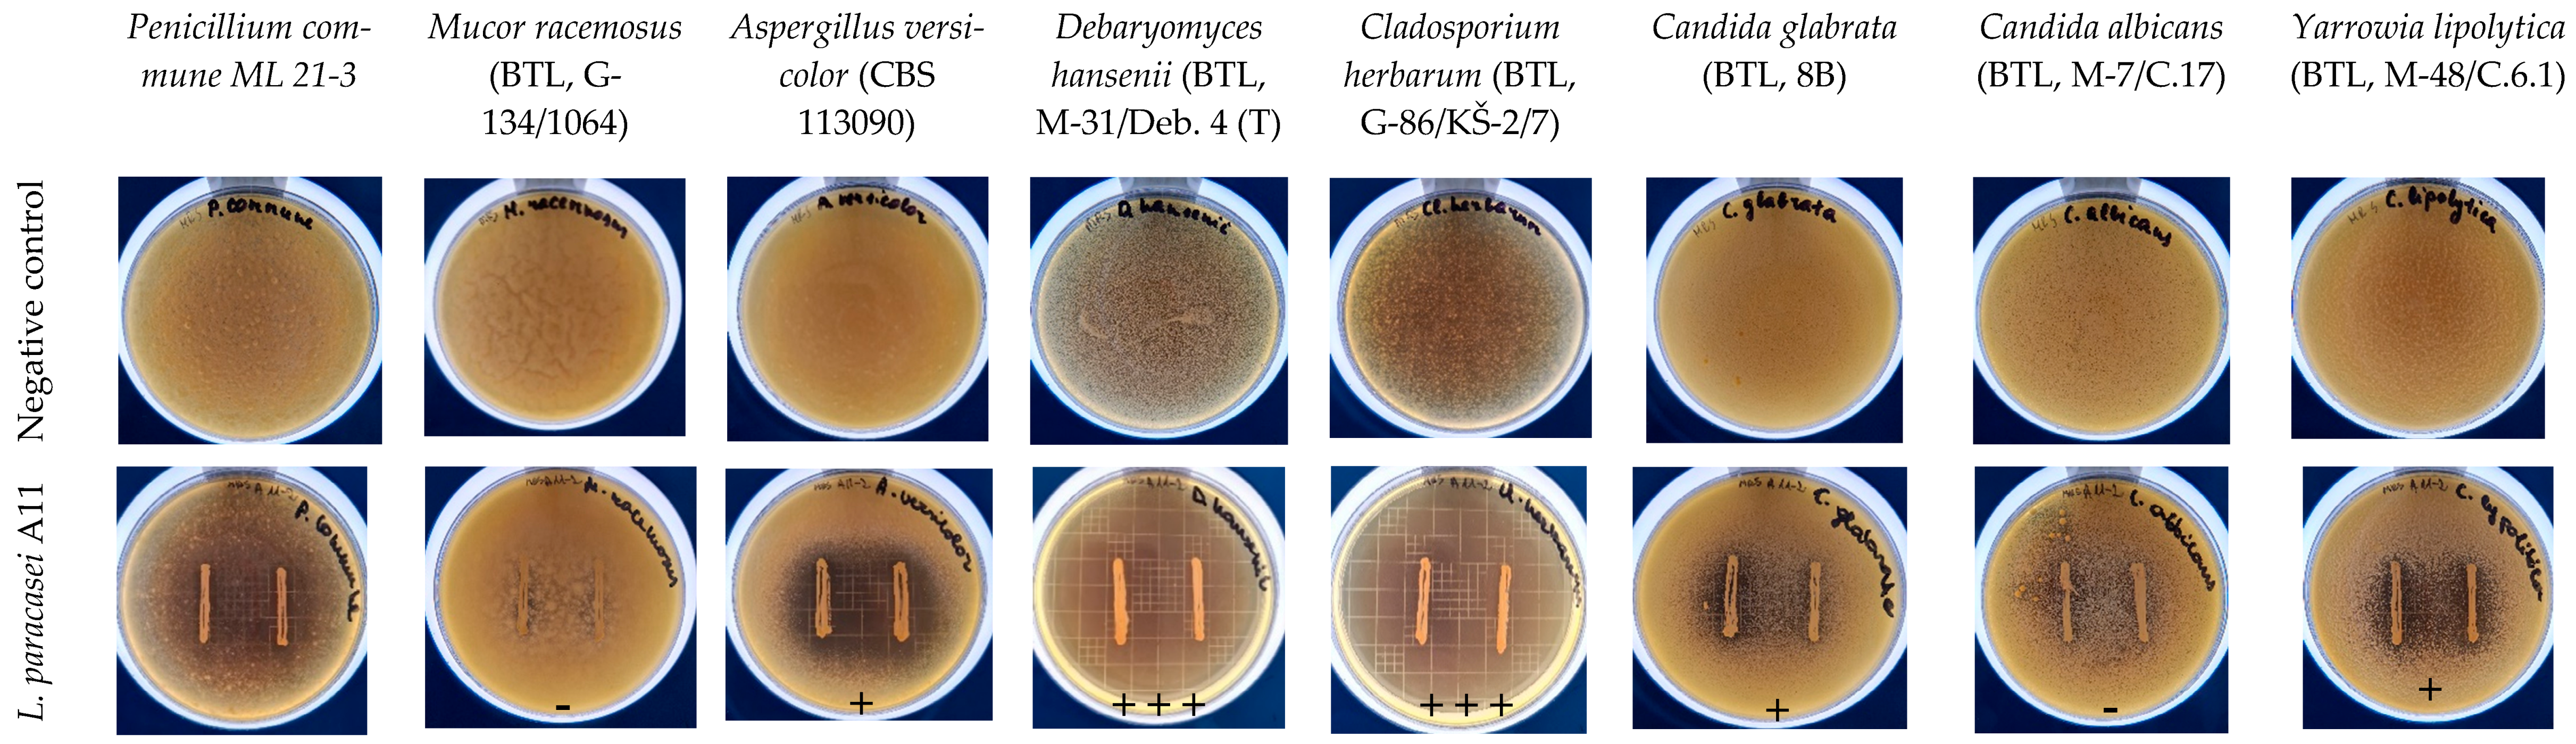

Screening for Antifungal Indigenous Lactobacilli Strains Isolated from Local Fermented Milk for Developing Bioprotective Fermentates and Coatings Based on Acid Whey Protein Concentrate for Fresh Cheese Quality Maintenance
Abstract
1. Introduction
2. Materials and Methods
2.1. Materials
2.2. Identification of Lactic Acid Bacteria
2.3. Identification of Lactobacilli with MALDI-TOF MS Biotyper
2.4. Safety Assessment
2.4.1. Haemolytic Activity
2.4.2. Antibiotic Susceptibility
2.4.3. Enzymatic Activities
2.5. Antifungal Activity Assays of L. paracasei A11
2.6. Cultivation of L. paracasei A11 and Coating Preparation
2.6.1. Cultivation of L. paracasei A11 in AWPC
2.6.2. Coating Preparation
2.7. AWPC, AWPC Fermentate, and Coating Application on Acid-Curd Cheese
2.8. Sample Analysis
2.9. Statistical Analysis
3. Results and Discussion
3.1. Haemolysis and Antibiotic Susceptibility Evaluation of Isolated Lactobacilli
3.2. Enzymatic Activity Evaluation of Lactobacilli
3.3. Inhibition of Yeasts and Moulds by L. paracasei A11
3.4. Growth of L. paracasei A11 in AWPC
3.5. Evaluation of Antifungal Activity of L. paracasei A11 Fermentate and Coatings on Acid-Curd Cheese
4. Conclusions
Author Contributions
Funding
Data Availability Statement
Conflicts of Interest
References
- Mileriene, J.; Serniene, L.; Henriques, M.; Gomes, D.; Pereira, C.; Kondrotiene, K.; Kasetiene, N.; Lauciene, L.; Sekmokiene, D.; Malakauskas, M. Effect of Liquid Whey Protein Concentrate–Based Edible Coating Enriched with Cinnamon Carbon Dioxide Extract on the Quality and Shelf Life of Eastern European Curd Cheese. J. Dairy Sci. 2021, 104, 1504–1517. [Google Scholar] [CrossRef]
- FAO. Climate Change, Agriculture and Food Security; FAO: Rome, Italy, 2016. [Google Scholar]
- European Parliament and of the Council Regulation 852/2004/EC on the hygiene of foodstuffs. Off. J. 2004, 139, 1–54. Available online: https://eur-lex.europa.eu/eli/reg/2004/852/oj (accessed on 1 February 2023).
- Rodríguez, L.G.R.; Mohamed, F.; Bleckwedel, J.; Medina, R.; De Vuyst, L.; Hebert, E.M.; Mozzi, F. Diversity and Functional Properties of Lactic Acid Bacteria Isolated from Wild Fruits and Flowers Present in Northern Argentina. Front. Microbiol. 2019, 10, 1091. [Google Scholar] [CrossRef] [PubMed]
- Siedler, S.; Rau, M.H.; Bidstrup, S.; Vento, J.M.; Aunsbjerg, S.D.; Bosma, E.F.; Mcnair, L.M.; Beisel, C.L.; Neves, A.R. Competitive Exclusion Is a Major Bioprotective Mechanism of Lactobacilli against Fungal Spoilage in Fermented Milk Products. Appl. Environ. Microbiol. 2020, 86, e02312-19. [Google Scholar] [CrossRef] [PubMed]
- FDA. Microorganisms & Microbial-Derived Ingredients Used in Food (Partial List); FDA: Silver Spring, MD, USA, 2018.
- Koutsoumanis, K.; Allende, A.; Alvarez-Ordóñez, A.; Bolton, D.; Bover-Cid, S.; Chemaly, M.; Davies, R.; De Cesare, A.; Hilbert, F.; Lindqvist, R.; et al. Update of the List of QPS-Recommended Biological Agentsintentionally Added to Food or Feed as Notified to EFSA 11:Suitability of Taxonomic Units Notified to EFSA UntilSeptember 2019. EFSA J. 2020, 18, e05965. [Google Scholar]
- Domingos-Lopes, M.F.P.; Stanton, C.; Ross, P.R.; Dapkevicius, M.L.E.; Silva, C.C.G. Genetic Diversity, Safety and Technological Characterization of Lactic Acid Bacteria Isolated from Artisanal Pico Cheese. Food Microbiol. 2017, 63, 178–190. [Google Scholar] [CrossRef]
- Costa, M.J.; Maciel, L.C.; Teixeira, J.A.; Vicente, A.A.; Cerqueira, M.A. Use of Edible Films and Coatings in Cheese Preservation: Opportunities and Challenges; Elsevier Ltd.: Amsterdam, The Netherlands, 2018; Volume 107, pp. 84–92. [Google Scholar]
- Díaz-Montes, E.; Castro-Muñoz, R. Edible Films and Coatings as Food-Quality Preservers: An Overview. Foods 2021, 10, 249. [Google Scholar] [CrossRef] [PubMed]
- Balciunas, E.M.; Martinez, F.A.C.; Todorov, S.D.; de Melo Franco, B.D.G.; Converti, A.; de Souza Oliveira, R.P. Novel Biotechnological Applications of Bacteriocins: A Review. Food Control 2013, 32, 134–142. [Google Scholar] [CrossRef]
- Valdés, A.; Ramos, M.; Beltrán, A.; Jiménez, A.; Garrigós, M.C. State of the Art of Antimicrobial Edible Coatings for Food Packaging Applications. Coatings 2017, 7, 56. [Google Scholar] [CrossRef]
- Silva, C.C.G.; Silva, S.P.M.; Ribeiro, S.C. Application of Bacteriocins and Protective Cultures in Dairy Food Preservation. Front. Microbiol. 2018, 9, 594. [Google Scholar] [CrossRef]
- Ramos, Ó.L.; Pereira, J.O.; Silva, S.I.; Fernandes, J.C.; Franco, M.I.; Lopes-da-Silva, J.A.; Pintado, M.E.; Malcata, F.X. Evaluation of Antimicrobial Edible Coatings from a Whey Protein Isolate Base to Improve the Shelf Life of Cheese. J. Dairy Sci. 2012, 95, 6282–6292. [Google Scholar] [CrossRef] [PubMed]
- Henriques, M.; Gomes, D.; Pereira, C. Whey Protein Edible Coatings: Recent Developments and Applications. In Food Engineering Series; Springer: Berlin/Heidelberg, Germany, 2016; pp. 177–196. [Google Scholar]
- Trajkovska Petkoska, A.; Daniloski, D.; D’Cunha, N.M.; Naumovski, N.; Broach, A.T.; Petkoska, A.T.; Daniloski, D.; D’Cunha, N.M.; Naumovski, N.; Broach, A.T. Edible Packaging: Sustainable Solutions and Novel Trends in Food Packaging. Food Res. Int. 2021, 140, 109981. [Google Scholar] [CrossRef]
- Mileriene, J.; Serniene, L.; Kondrotiene, K.; Lauciene, L.; Andruleviciute, V.; Kasetiene, N.; Sekmokiene, D.; Malakauskas, M. Effect of Indigenous Lactococcus Lactis on Physicochemical and Sensory Properties of Thermo-Coagulated Acid Whey Protein. J. Food Process. Preserv. 2021, 45, e15420. [Google Scholar] [CrossRef]
- Fang, T.; Shen, X.; Hou, J.; Guo, M. Effects of Polymerized Whey Protein Prepared Directly from Cheese Whey as Fat Replacer on Physiochemical, Texture, Microstructure and Sensory Properties of Low-Fat Set Yogurt. LWT 2019, 115, 108268. [Google Scholar] [CrossRef]
- Kirmaci, H.A.; Özer, B.H.; Akçelik, M.; Akçelik, N. Identification and Characterisation of Lactic Acid Bacteria Isolated from Traditional Urfa Cheese. Int. J. Dairy Technol. 2016, 69, 301–307. [Google Scholar] [CrossRef]
- Dudkiewicz, M.; Berłowska, J.; Kręgiel, D. Acid Whey as a Medium for Cultivation of Conventional and Non-Conventional Yeasts. Biotechnol. Food Sci. 2016, 80, 75–82. [Google Scholar]
- Mondragón-Parada, M.E.; Nájera-Martínez, M.; Juárez-Ramírez, C.; Galíndez-Mayer, J.; Ruiz-Ordaz, N.; Cristiani-Urbina, E. Lactic Acid Bacteria Production from Whey. Appl. Biochem. Biotechnol. 2006, 134, 223–232. [Google Scholar] [CrossRef]
- Taye, Y.; Degu, T.; Fesseha, H.; Mathewos, M. Isolation and Identification of Lactic Acid Bacteria from Cow Milk and Milk Products. Sci. World J. 2021, 2021, 1–6. [Google Scholar] [CrossRef]
- Dec, M.; Urban-Chmiel, R.; Gnat, S.; Puchalski, A.; Wernicki, A. Identification of Lactobacillus Strains of Goose Origin Using MALDI-TOF Mass Spectrometry and 16S–23S RDNA Intergenic Spacer PCR Analysis. Res. Microbiol. 2014, 165, 190–201. [Google Scholar] [CrossRef] [PubMed]
- Maragkoudakis, P.A.; Mountzouris, K.C.; Psyrras, D.; Cremonese, S.; Fischer, J.; Cantor, M.D.; Tsakalidou, E. Functional Properties of Novel Protective Lactic Acid Bacteria and Application in Raw Chicken Meat against Listeria Monocytogenes and Salmonella Enteritidis. Int. J. Food Microbiol. 2009, 130, 219–226. [Google Scholar] [CrossRef]
- Guidance on the Assessment of Bacterial Susceptibility to Antimicrobials of Human and Veterinary Importance. EFSA J. 2012, 10, 2740. [CrossRef]
- Kondrotiene, K.; Lauciene, L.; Andruleviciute, V.; Kasetiene, N.; Serniene, L.; Sekmokiene, D.; Malakauskas, M. Safety Assessment and Preliminary In Vitro Evaluation of Probiotic Potential of Lactococcus Lactis Strains Naturally Present in Raw and Fermented Milk. Curr. Microbiol. 2020, 1, 3. [Google Scholar] [CrossRef]
- Magnusson, J.; Ström, K.; Roos, S.; Sjögren, J.; Schnürer, J. Broad and Complex Antifungal Activity among Environmental Isolates of Lactic Acid Bacteria. FEMS Microbiol. Lett. 2003, 219, 129–135. [Google Scholar] [CrossRef] [PubMed]
- ISO-ISO 22184:2021; Milk and Milk Products—Determination of the Sugar Contents—High Per-Formance Anion Exchange Chromatography with Pulsed Amperometric Detection Method (HPAEC-PAD). International Organization for Standardization: Geneva, Switzerland, 2021.
- ISO-ISO 8069:2005; Dried Milk—Determination of Content of Lactic Acid and Lactates. International Organization for Standardization: Geneva, Switzerland, 2005.
- ISO 15214:1998; Microbiology of Food and Animal Feeding Stuffs—Horizontal Method for the Enumeration of Mesophilic Lactic Acid Bacteria—Colony-Count Technique at 30 Degrees C 1998. International Organization for Standardization: Geneva, Switzerland, 1998.
- ISO 6611:2004; Milk and Milk Products—Enumeration of Colony-Forming Units of Yeasts and/or Moulds—Colony-Count Technique at 25 Degrees C. International Organization for Standardization: Geneva, Switzerland, 2004.
- ISO 21528-2:2017; Microbiology of the Food Chain—Horizontal Method for the Detection and Enumeration of Enterobacteriaceae—Part 2: Colony-Count Technique. International Organization for Standardization: Geneva, Switzerland, 2017.
- ISO 8586:2012; I. Sensory Analysis—General Guidelines for the Selection, Training and Monitoring of Selected Assessors and Expert Sensory Assessors 2012, 28. International organisation for standartisation: Geneva, Switzerland, 2012.
- Mangia, N.P.; Saliba, L.; Deiana, P.; Mangia, N.P.; Saliba, L.; Deiana, P.; Mangia, N.P.; Saliba, L.; Deiana, P. Functional and Safety Characterization of Autochthonous Lactobacillus Paracasei FS103 Isolated from Sheep Cheese and Its Survival in Sheep and Cow Fermented Milks during Cold Storage. Ann. Microbiol. 2019, 69, 161–170. [Google Scholar] [CrossRef]
- Bujnakova, D.; Strakova, E. Safety, Probiotic and Technological Properties of Lactobacilli Isolated from Unpasteurised Ovine and Caprine Cheeses. Ann. Microbiol. 2017, 67, 813–826. [Google Scholar] [CrossRef]
- Nami, Y.; Haghshenas, B.; Bakhshayesh, R.V.; Jalaly, H.M.; Lotfi, H.; Eslami, S.; Hejazi, M.A. Novel Autochthonous Lactobacilli with Probiotic Aptitudes as a Main Starter Culture for Probiotic Fermented Milk. LWT 2018, 98, 85–93. [Google Scholar] [CrossRef]
- Saxami, G.; Papadopoulou, O.S.; Chorianopoulos, N.; Kourkoutas, Y.; Tassou, C.C.; Galanis, A. Molecular Detection of Two Potential Probiotic Lactobacilli Strains and Evaluation of Their Performance as Starter Adjuncts in Yogurt Production. Int. J. Mol. Sci. 2016, 17, 668. [Google Scholar] [CrossRef]
- Erginkaya, Z.; Turhan, E.U.; Tatlı, D. Determination of Antibiotic Resistance of Lactic Acid Bacteria Isolated from Traditional Turkish Fermented Dairy Products. Iran. J. Vet. Res. 2018, 19, 53–56. [Google Scholar]
- Anisimova, E.A.; Yarullina, D.R. Antibiotic Resistance of LACTOBACILLUS Strains. Curr. Microbiol. 2019, 76, 1407–1416. [Google Scholar] [CrossRef]
- Klare, I.; Konstabel, C.; Werner, G.; Huys, G.; Vankerckhoven, V.; Kahlmeter, G.; Hildebrandt, B.; Müller-Bertling, S.; Witte, W.; Goossens, H. Antimicrobial Susceptibilities of Lactobacillus, Pediococcus and Lactococcus Human Isolates and Cultures Intended for Probiotic or Nutritional Use. J. Antimicrob. Chemother. 2007, 59, 900–912. [Google Scholar] [CrossRef]
- Drago, L. Probiotics and Colon Cancer. Microorganisms 2019, 7, 66. [Google Scholar] [CrossRef]
- Barbieri, F.; Montanari, C.; Gardini, F.; Tabanelli, G. Biogenic Amine Production by Lactic Acid Bacteria: A Review. Foods 2019, 8, 17. [Google Scholar] [CrossRef]
- Muñoz-Atienza, E.; Gómez-Sala, B.; Araújo, C.; Campanero, C.; Del Campo, R.; Hernández, P.E.; Herranz, C.; Cintas, L.M. Antimicrobial Activity, Antibiotic Susceptibility and Virulence Factors of Lactic Acid Bacteria of Aquatic Origin Intended for Use as Probiotics in Aquaculture. BMC Microbiol. 2013, 13, 1–22. [Google Scholar] [CrossRef]
- Garnier, L.; Valence, F.; Mounier, J. Diversity and Control of Spoilage Fungi in Dairy Products: An Update. Microorganisms 2017, 5, 42. [Google Scholar] [CrossRef] [PubMed]
- Cheong, E.Y.L.; Sandhu, A.; Jayabalan, J.; Le, T.T.K.; Nhiep, N.T.; Ho, H.T.M.; Zwielehner, J.; Bansal, N.; Turner, M.S. Isolation of Lactic Acid Bacteria with Antifungal Activity against the Common Cheese Spoilage Mould Penicillium Commune and Their Potential as Biopreservatives in Cheese. Food Control 2014, 46, 91–97. [Google Scholar] [CrossRef]
- Kure, C.F.; Skaar, I. The Fungal Problem in Cheese Industry. Curr. Opin. Food Sci. 2019, 29, 14–19. [Google Scholar] [CrossRef]
- Ramos-Pereira, J.; Mareze, J.; Fernández, D.; Rios, E.A.; Santos, J.A.; López-Díaz, T.M. Antifungal Activity of Lactic Acid Bacteria Isolated from Milk against Penicillium Commune, P. Nordicum, and P. Verrucosum. Int. J. Food Microbiol. 2021, 355, 109331. [Google Scholar] [CrossRef]
- Fernandez, B.; Vimont, A.; Desfossés-Foucault, É.; Daga, M.; Arora, G.; Fliss, I. Antifungal Activity of Lactic and Propionic Acid Bacteria and Their Potential as Protective Culture in Cottage Cheese. Food Control 2017, 78, 350–356. [Google Scholar] [CrossRef]
- Tremonte, P.; Pannella, G.; Succi, M.; Tipaldi, L.; Sturchio, M.; Coppola, R.; Luongo, D.; Sorrentino, E. Antimicrobial Activity of Lactobacillus Plantarum Strains Isolated from Different Environments: A Preliminary Study. Int. Food Res. J. 2017, 24, 852–859. [Google Scholar]
- Colombo, M.; Nero, L.A.; Todorov, S.D. Safety Profiles of Beneficial Lactic Acid Bacteria Isolated from Dairy Systems. Braz. J. Microbiol. 2020, 51, 787–795. [Google Scholar] [CrossRef]
- Mileriene, J.; Serniene, L.; Kondrotiene, K.; Lauciene, L.; Kasetiene, N.; Sekmokiene, D.; Andruleviciute, V.; Malakauskas, M. Quality and Nutritional Characteristics of Traditional Curd Cheese Enriched with Thermo-coagulated Acid Whey Protein and Indigenous Lactococcus Lactis Strain. Int. J. Food Sci. Technol. 2020, 56, 2853–2863. [Google Scholar] [CrossRef]
- Bassi, D.; Gazzola, S.; Sattin, E.; Bello, F.D.; Simionati, B.; Cocconcelli, P.S. Lactic Acid Bacteria Adjunct Cultures Exert a Mitigation Effect against Spoilage Microbiota in Fresh Cheese. Microorganisms 2020, 8, 1199. [Google Scholar] [CrossRef] [PubMed]
- Aunsbjerg, S.D.; Honoré, A.H.; Marcussen, J.; Ebrahimi, P.; Vogensen, F.K.; Benfeldt, C.; Skov, T.; Knøchel, S. Contribution of Volatiles to the Antifungal Effect of Lactobacillus Paracasei in Defined Medium and Yogurt. Int. J. Food Microbiol. 2015, 194, 46–53. [Google Scholar] [CrossRef] [PubMed]
- Aljewicz, M.; Cichosz, G. Protective Effects of Lactobacillus Cultures in Dutch-Type Cheese-like Products. LWT 2015, 63, 52–56. [Google Scholar] [CrossRef]

| Isolate | Identification | Haemolysis | Ampicillin | Erythromycin | Clindamycin | Chloramphenicol | Streptomycin | Gentamycin | Kanamycin | Vancomycin | Tetracycline |
|---|---|---|---|---|---|---|---|---|---|---|---|
| A161-1 | L. paracasei | γ | 1 (4) | 0.19 (1) | 0.50 (1) | 6 (4) | 24 (64) | 4 (32) | 64 (64) | >256 (n.r.) | 0.5 (4) |
| A11 | L. paracasei | γ | 0.75 (4) | 0.19 (1) | 0.64 (1) | 4 (4) | 12 (64) | 6 (32) | 24 (64) | >256 (n.r.) | 0.5 (4) |
| A173-2 | L. paracasei | γ | 0.75 (4) | 0.25 (1) | 0.75 (1) | 8 (4) | 24 (64) | 6 (32) | 48 (64) | >256 (n.r.) | 0.75 (4) |
| A154-d1 | L. plantarum | γ | 0.125 (2) | 0.25 (1) | 0.75 (2) | 6 (8) | 8 (n.r.) | 3 (16) | 12 (64) | >256 (n.r.) | 4 (32) |
| PR33 | L. plantarum | γ | 0.032 (2) | 0.5 (1) | <0.016 (2) | 2 (8) | 32 (n.r.) | 4 (16) | 64 (64) | >256 (n.r.) | 6 (32) |
| L1 | L. rhamnosus | α | 0.75 (4) | 0.94 (1) | 0.75 (1) | 16 (4) | 4 (32) | 1.5 (16) | 8 (64) | >256 (n.r.) | 0.75 (8) |
| PR21 | L. plantarum | γ | 0.032 (2) | 0.19 (1) | 0.047 (2) | 2 (8) | 64 (n.r.) | 12 (16) | >256 (64) | >256 (n.r.) | 2 (32) |
| PR23 | L. plantarum | γ | 0.047 (2) | 0.38 (1) | 0.047 (2) | 4 (8) | 64 (n.r.) | 12 (16) | >256 (64) | >256 (n.r.) | 6 (32) |
| PR35 | L. plantarum | γ | 0.047 (2) | 0.38 (1) | 0.016 (2) | 4 (8) | 48 (n.r.) | 4 (16) | 96 (64) | >256 (n.r.) | 6 (32) |
| PR41 | L. amylovorus | γ | 0.19 (1) | 0.38 (1) | 0.38 (1) | 8 (4) | 6 (16) | 2 (16) | 12 (16) | >256 (2) | 12 (4) |
| R111 | L. paracasei | γ | 0.094 (4) | <0.016 (1) | 0.47 (1) | 8 (4) | 16 (64) | 3 (32) | 32 (64) | >256 (n.r.) | 1,5 (4) |
| R112 | L. paracasei | γ | <0.016 (4) | <0.016 (1) | 0.19 (1) | 8 (4) | 8 (64) | 4 (32) | 192 (64) | >256 (n.r.) | 0.75 (4) |
| Enzyme | Lactobacilli Isolates | ||
|---|---|---|---|
| A11 | A154-d1 | PR33 | |
| Alkaline phosphatase | 0 | 0 | 0 |
| Esterase (C4) | 2 | 0 | 0 |
| Esterase lipase (C8) | 1 | 0 | 0 |
| Lipase (C14) | 0 | 0 | 0 |
| Leucine arylamidase | 5 | 4 | 4 |
| Valine arylamidase | 5 | 3 | 4 |
| Cystine arylamidase | 1 | 0 | 1 |
| Trypsin | 0 | 0 | 0 |
| Alpha-chymotrypsin | 1 | 0 | 0 |
| Acid phosphatase | 2 | 0 | 0 |
| Naphthol-AS-BI phosphohydrolase | 3 | 2 | 2 |
| Alpha-galactosidase | 0 | 0 | 0 |
| Beta-galactosidase | 0 | 3 | 3 |
| Beta-glucuronidase | 0 | 0 | 0 |
| Alpha-glucosidase | 4 | 0 | 3 |
| Beta-glucosidase | 0 | 4 | 4 |
| N-Acetyl-beta-glucosaminidase | 0 | 4 | 2 |
| Alpha-mannosidase | 0 | 0 | 0 |
| Alpha-fucosidase | 0 | 0 | 0 |
| Parameter | Growth Media | |||
|---|---|---|---|---|
| MRS Broth | AWPC | |||
| 0 h | 48 h | 0 h | 48 h | |
| Glucose (%) | 1.83 ± 0.19 ***a | 0.28 ± 0.12 *a | 0.66 ± 0.01 ***b | 0.57 ± 0.03 *b |
| Galactose (%) | - | - | 1.05 ± 0.04 *** | 0.97 ± 0.03 *** |
| Lactose (%) | - | - | 9.84 ± 0.06 *** | 9.75 ± 0.09 *** |
| D/L lactic acid (mg/100 g) | 34.45 ± 0.46 ***a | 1481.85 ± 51.99 *a | 847.03 ± 1.65 ***b | 1030.70 ± 58.85 *b |
| D/L lactate (mg/100 g) | 34.06 ± 0.45 ***a | 1465.50 ± 51.41 *a | 837.62 ± 1.63 ***b | 1019.26 ± 58.19 *b |
Disclaimer/Publisher’s Note: The statements, opinions and data contained in all publications are solely those of the individual author(s) and contributor(s) and not of MDPI and/or the editor(s). MDPI and/or the editor(s) disclaim responsibility for any injury to people or property resulting from any ideas, methods, instructions or products referred to in the content. |
© 2023 by the authors. Licensee MDPI, Basel, Switzerland. This article is an open access article distributed under the terms and conditions of the Creative Commons Attribution (CC BY) license (https://creativecommons.org/licenses/by/4.0/).
Share and Cite
Vasiliauskaite, A.; Mileriene, J.; Kasparaviciene, B.; Aleksandrovas, E.; Songisepp, E.; Rud, I.; Axelsson, L.; Muizniece-Brasava, S.; Ciprovica, I.; Paskevicius, A.; et al. Screening for Antifungal Indigenous Lactobacilli Strains Isolated from Local Fermented Milk for Developing Bioprotective Fermentates and Coatings Based on Acid Whey Protein Concentrate for Fresh Cheese Quality Maintenance. Microorganisms 2023, 11, 557. https://doi.org/10.3390/microorganisms11030557
Vasiliauskaite A, Mileriene J, Kasparaviciene B, Aleksandrovas E, Songisepp E, Rud I, Axelsson L, Muizniece-Brasava S, Ciprovica I, Paskevicius A, et al. Screening for Antifungal Indigenous Lactobacilli Strains Isolated from Local Fermented Milk for Developing Bioprotective Fermentates and Coatings Based on Acid Whey Protein Concentrate for Fresh Cheese Quality Maintenance. Microorganisms. 2023; 11(3):557. https://doi.org/10.3390/microorganisms11030557
Chicago/Turabian StyleVasiliauskaite, Agne, Justina Mileriene, Beatrice Kasparaviciene, Elvidas Aleksandrovas, Epp Songisepp, Ida Rud, Lars Axelsson, Sandra Muizniece-Brasava, Inga Ciprovica, Algimantas Paskevicius, and et al. 2023. "Screening for Antifungal Indigenous Lactobacilli Strains Isolated from Local Fermented Milk for Developing Bioprotective Fermentates and Coatings Based on Acid Whey Protein Concentrate for Fresh Cheese Quality Maintenance" Microorganisms 11, no. 3: 557. https://doi.org/10.3390/microorganisms11030557
APA StyleVasiliauskaite, A., Mileriene, J., Kasparaviciene, B., Aleksandrovas, E., Songisepp, E., Rud, I., Axelsson, L., Muizniece-Brasava, S., Ciprovica, I., Paskevicius, A., Aksomaitiene, J., Gabinaitiene, A., Uljanovas, D., Baliukoniene, V., Lutter, L., Malakauskas, M., & Serniene, L. (2023). Screening for Antifungal Indigenous Lactobacilli Strains Isolated from Local Fermented Milk for Developing Bioprotective Fermentates and Coatings Based on Acid Whey Protein Concentrate for Fresh Cheese Quality Maintenance. Microorganisms, 11(3), 557. https://doi.org/10.3390/microorganisms11030557

